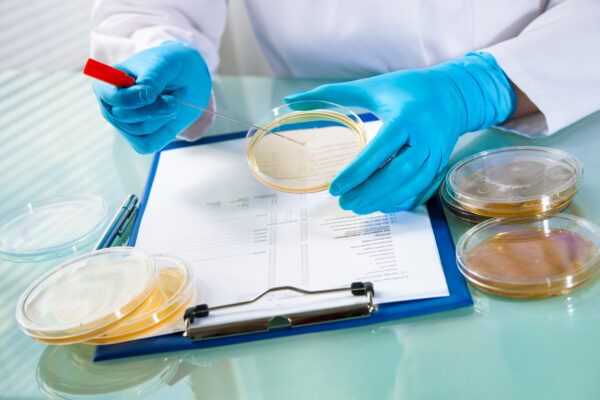
Petri dishes Petri dishes

A Neoteric antibacterial ceria-silver nanozyme for abiotic surfaces
Control of bacterial infections on abiotic surfaces represents a critical challenge in healthcare, imposing significant burdens on both healthcare workers and the economy. With community-associated and hospital-acquired infections continuing to pose major global health threats, innovative solutions are urgently needed to enhance disinfection practices. In this article, we delve into a groundbreaking study on a…